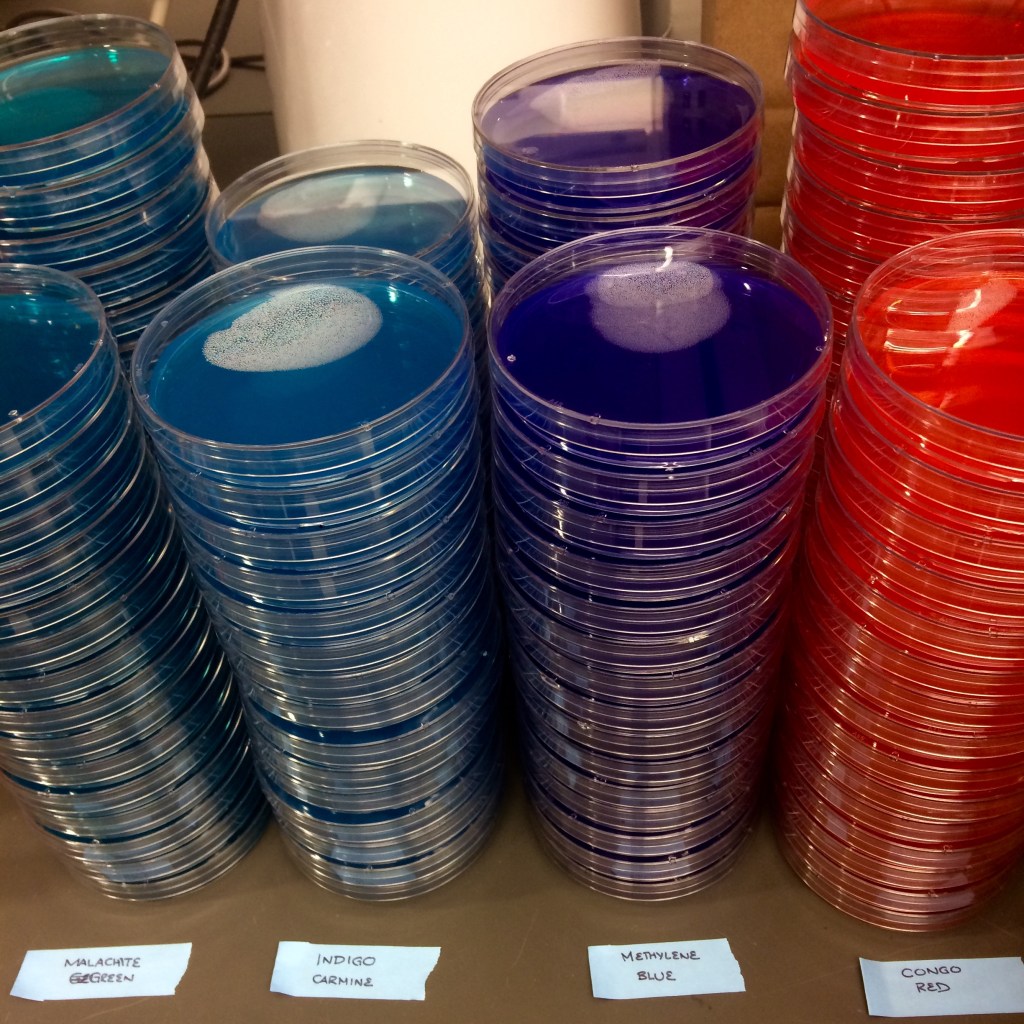

Come join a dynamic group of microbiologists, microbial ecologists, biogeochemists and bioinformaticians! Students who work in my lab can expect to perform cutting-edge research, gain experience in teaching and mentoring, and rely on the support of a group interested in your professional and personal well-being. Support is for three years as a research assistant, including summers & health insurance, with funds available for one national or international meeting per year and one local meeting per year to grow your network and share your research progress.

This project will provide graduate student training in research and teaching, as well as undergraduate and high school student training in microbial physiology, ecology and genomics. Understanding bacterial adaptation might help to explain the non-linear pattern of soil C loss over decades of chronic warming, and would define how environmental controls over the carbon cycle may act in a non-linear over longer time scales.

Microbes are important components of every living system, and microbes always live in communities. Microbial communities have emergent properties that are a function of their physiology, ecology and evolution.
As Earth’s climate changes, warming temperatures threaten the ability for soil to effectively store carbon, reducing the beneficial ecosystem services that soils provide and releasing stored carbon to the atmosphere. In a 25-year long field experiment ongoing in a temperate forest in central Massachusetts, chronic soil warming has resulted in a large loss of soil carbon as carbon dioxide. The loss is mostly due to microbes, with periods of soil carbon decay punctuated by changes in microbial communities.
This research is designed to evaluate the central hypothesis that soil bacteria have acquired traits associated with adaptation to decades of chronic soil warming. We are hiring a graduate student to understand evolutionary adaptation of individual bacteria to long-term warming. Isolates will be screened for traits associated with oligotrophy and degradation of complex carbon. A subset of species with ecophysiology data will also be sequenced for evolutionary genomics.
Please contact Dr. DeAngelis for more information about this opportunity, which is available now. In your email, please attach your CV, a brief statement of research interests, and the contact information for at least three professional references. Priority will be given to students interested in enrolling in the Microbiology graduate program, though I also accept students through OEB and Plant Biology graduate programs.